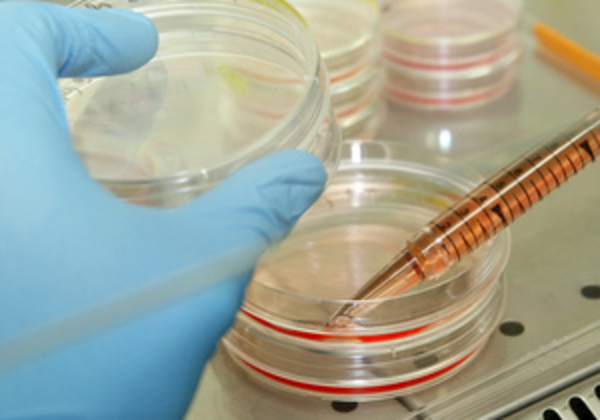
Вакцина для предотвращения рецидива рака груди прошла вторую стадию клинических испытаний

Вакцина для предотвращения рецидива рака груди прошла вторую стадию клинических испытаний
Результаты работы Элизабет Миттендорф (Elizabeth Mittendorf) и ее коллег из хьюстонского Центра изучения рака при Техасском университете (The University of Texas MD Anderson Cancer Center) будут представлены в июне на Ежегодном собрании Американского общества клинической онкологии (American Society of Clinical Oncology).
Вакцина, названная учеными AE37, увеличивает активность иммунной системы, направленную против рецептора эпидермального фактора роста второго типа (HER2) - белка, который способствует росту опухоли. HER2 экспрессируется в клетках рака груди и присутствует у 75-80 процентов пациентов. Вакцина содержит один из участков этого белка.
Ученые случайном образом выбрали 201 участника исследования, которые вылечились от рака груди. Их разделили на две группы: первая группа (103 человека) получала вакцинацию, вторая группа (98 человек) являлась контрольной.
Рецидив заболевания наблюдался у 10,3 процента женщин из первой группы и у 18 процентов женщин из второй группы. Таким образом, вакцинация уменьшила риск рецидива на 43 процента и была действенна у женщин с различным уровнем экспрессии HER2.
Побочные эффекты, вызванные применением вакцины, были незначительными и кратковременными. Среди них - покраснение небольшого участка кожи около места укола, симптомы простуды и боли в костях.
"Благодаря вакцине иммунная система женщин, которые уже страдали от рака молочных желез, учится немедленно распознавать клетки опухоли и атаковать их", - отметила Миттендорф.
Ранее стало известно, что стресс в результате ухода за женой, страдающей раком груди, может нарушить здоровье мужчины. Последствия могут проявляться и годы спустя после окончания лечения.






